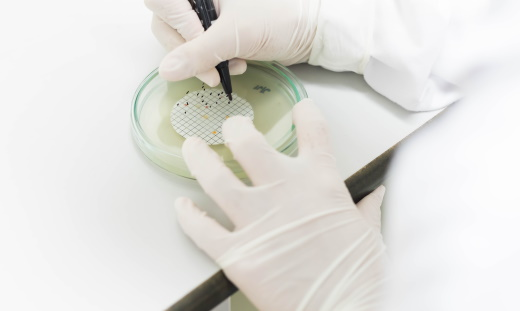
Microbiology hand counting microbiology plate

针式滤器信息图
GD/X 针式滤器,带有预滤器,用于难以过滤或黏性样品。

在药物检测中,实验室过滤对于确保获得一致且可靠的结果至关重要。Cytiva 提供多种产品来支持分析检测和其他应用,例如溶出度检测和脂质体挤出。严格按照质量标准在 ISO 认证设施中生产产品。

任何药物溶出度检测的目的是获取关键的药物释放信息,即活性药物成分 (API) 从其固体剂型中的释放速率,这对于药物质量控制(药物 QC)和药物开发至关重要。过滤对于检测结果的一致性和可靠性至关重要。

Cytiva 过滤产品可高效过滤样品以用于 HPLC,在实验室处理大量 HPLC 样品时可帮助其节省时间。此项技术有助于减少过滤装置的数量,降低相关成本及浪费,同时保护贵重仪器,从而获得一致的分析检测结果。
不同的微生物检测针对不同的目标微生物,使用适合目标微生物的高质量膜过滤器对检测成功至关重要。